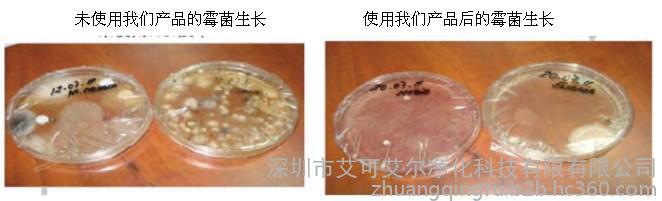

| 安装方式 | 镶嵌式植入型 |
|---|---|
| 功率 | 19W |
| 使用寿命 | 20000小时(约8-10年) |
| 是否增加风阻 | 不会增加设别风阻 |
| 技术原理 | 光电离子化技术 |
| 技术类型 | 主动式净化 |
| 产地 | 美国 |
| 产品别名 | 风管植入式空气净化器 |
| 产品规格 | 25*25*29cm |
| 产品类别 | 风管镶嵌式净化器 |
| 产品型号 | ActivTek INDUCT2000 |
| 产品用途 | 除烟除尘、分解甲醛苯、隔离传染病毒、杀菌灭螨、制造活性负氧离子 |
| 规格 | 交流电 |
| 控制方式 | 可单独遥控控制、可与空调设备联动 |
| 适用范围 | 家用/商用、地铁以及公共设施 |
| 适用面积 | 186平方米 |
| 颜色 | 太空银 |
| 品牌 | 美国艾可艾尔中央空调配套空气净化器 |
| 加工定制 | 是 |
| 适用星级 | 五星级 |
| 滤网类型 | 无 |

深圳市艾可艾尔净化科技有限公司所代理美国Activtek空气净化器产品。美国activTek是空气净化领域成功的开拓者和**者**activTek环境是集团公司的重要成员,集团公司已有超过91年的在空气净化行业的成功的历史。在空气净化领域有开发、设计、测试以及使用的成功经验,为人类创造健康的室内环境。
美国activTek专注于提供空气净化产品涵盖了暖通空调行业,住宅及民用建筑行业,医院和制药行业,餐饮服务行业,食品加工行业和办公楼宇及商业场所。对于每一个细分市场,activTek持续不断进行技术创新和培训,开发新产品,以满足日益增长的需求,改善和保持人类健康的生活空间和室内环境

现在人们80%的时间都在室内度过,这个数值在城市里上升到了90%,室内环境健康程度与人们的身体健康息息相关。
在中央空调的现代化建筑中,由于建筑结构的密闭和节能方面的要求的增强,中央空调系统导致室内空气质量极差,异味严重,出现“亚健康““空调病” 等现象世界卫生组织将此定义为“致病建筑物综合症(SBS)”,中央空调为密闭空间,清洁不易,所以容易形成细菌病菌滋生的病床,后期容易随着空调的打开吹入写字楼内,形成一种异味源以及病菌源头。
中央电视台报道的关于**体育总局训练基地的感冒传染的原因**是由于在中央空调系统内有大量的细菌、病毒而引起。
传统的解决方式包括清洁、绿化、定期更换、喷洒、通风等,耗时耗力,且解决效率低下,不能彻底,长期反复。


艾可艾尔空气净化器拥有独特的仿制大自然的雷雨天气净化大气原理的独特光电离子化技术,产生多种活性净化因子释放到空气中,主动快速、高效的净化空气中的多种有害污染物质(PM2.5**、苯、细菌、病毒及螨虫等**还原成空气中的水和氧气,不会造成二次污染,且具有一定的增氧加湿功能,同时产生大量的负氧活性因子,给您森林般的呼吸感受!
在英美等发达**,产品经过多重检测,直接可用于无菌手术室内。

来自美国的空气品质专家——艾可艾尔(Activtek)
1.独特的光电离子化技术,主动出击,在室内空间快速高效地杀菌消毒、去异味、除尘、灭螨、隔离传染病等,为您和家人提供**时间的安全健康保证;
2.具有独立空调镶嵌式净化器,无需改变空调设计结构,不会增加风阻,不会影响空调设备的运行参数;
3.单机**大使用面积达930平方米仅20W功率,节能省电;
4.使用寿命长**低可达20000小时(约8-10年)
5.无需维护,无需更换耗材,节省后期维护成本
6.可制造出大量的负氧离子,给您森林般的居家环境












 生成海报
生成海报









